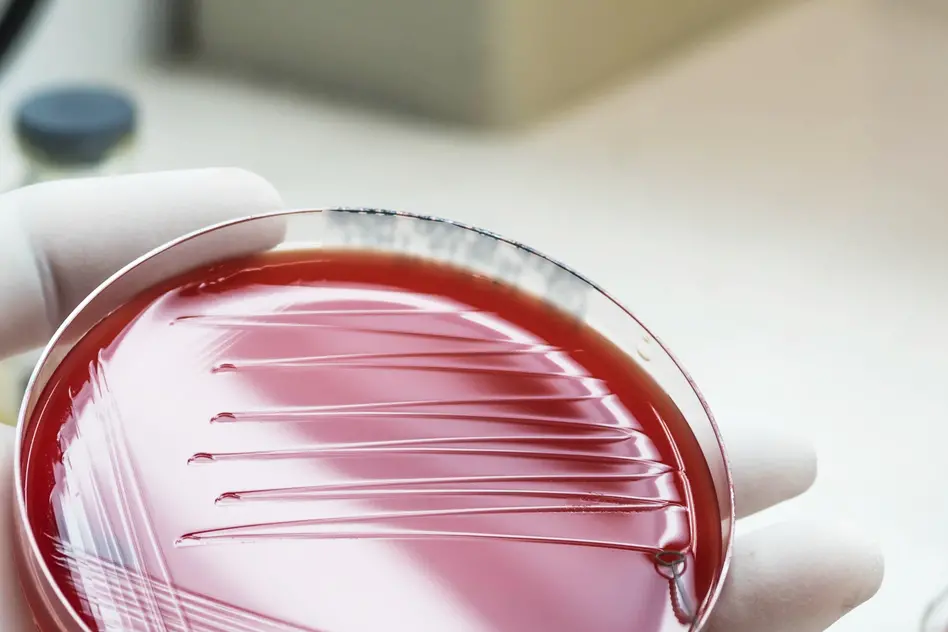

Londra. Non si ferma l'epidemia di meningite acuta «senza precedenti» che ha colpito il sud dell'Inghilterra nonostante le misure messe in campo finora nell'emergenza sanitaria. Sono saliti da 20 a 27 i casi, registrati in due università e quattro scuole nella contea del Kent, dove si è scatenato il focolaio riconducibile al batterio meningococco B (MenB). Mentre è stato segnalato anche un caso in un istituto di Londra ma sempre collegato a quanto sta accadendo da giorni nella storica città di Canterbury. È lì infatti che tutto è iniziato: in alcune serate al Club Chemistry, diventato la discoteca del contagio per i numerosi ragazzi e ragazze usciti dal locale con la malattia - trasmessa tramite il contatto ravvicinato - e poi ricoverati d'urgenza in ospedale.
Massima allerta
In una situazione per molti versi preoccupante è così entrato in vigore lo stato di allerta sanitaria pubblica, che prevede l'immediata segnalazione da parte di tutti i medici del servizio sanitario nazionale (Nhs) di eventuali sintomi sospetti, ovunque in Gran Bretagna. Si tratta di una misura preventiva non ordinaria, già adottata in anni recenti per altri casi di focolai infettivi come quello del cosiddetto “vaiolo delle scimmie” (Mpox), ma tra i giovani a rischio la paura resta alta. Lo stesso ministro della Sanità, Wes Streeting, è andato in visita a Canterbury per portare un messaggio rassicurante a fronte di un'epidemia che finora ha causato due morti, uno studente di 21 anni e una studentessa di 18. Come già fatto mercoledì dal premier laburista Keir Starmer in Parlamento, il ministro ha invitato chiunque sia stato nel nightclub a farsi avanti per ricevere sia una terapia antibiotica che il vaccino. Ma soprattutto la campagna di profilassi vaccinale è stata estesa negli atenei colpiti, la Kent University e la Canterbury Christ Church University, e avviata anche fra gli studenti degli ultimi due anni nelle scuole superiori dove sono stati segnalati i contagi. Streeting ha anche sottolineato che l'Nhs ha risposto velocemente all'allerta e che nonostante la diffusione rapida della malattia in un anno normale si registrano circa 350 casi di meningite B nel Paese, con segnalazioni quasi ogni giorno.
I dubbi
Le autorità sanitarie hanno precisato di «non poter ancora confermare che l'epidemia sia stata circoscritta». Come ha spiegato Robin May, responsabile scientifico dell'Agenzia per la sicurezza sanitaria del Regno Unito (Ukhsa), è «molto difficile sapere quale direzione prenderanno i contagi da qui in avanti». E ancora: «Si tratta di un focolaio molto insolito, molto più esteso di quanto ci aspetteremmo normalmente». Ha anche avanzato l'ipotesi che la ridotta socializzazione durante gli anni del Covid abbia reso i giovani meno immuni naturalmente alla malattia. Intanto la risposta del sistema sanitario è sotto osservazione, anche se non certo come ai tempi della pandemia, quando l'Nhs rischiò di “collassare”, come emerso dal rapporto pubblicato dalla commissione d'inchiesta sul coronavirus presieduta dalla giudice a riposo Heather Hallett.
RIPRODUZIONE RISERVATA
Questo contenuto è riservato agli utenti abbonati
Per continuare a leggere abbonati o effettua l'accesso se sei già abbonato.
• Accedi agli articoli premium
• Sfoglia il quotidiano da tutti i dispositivi